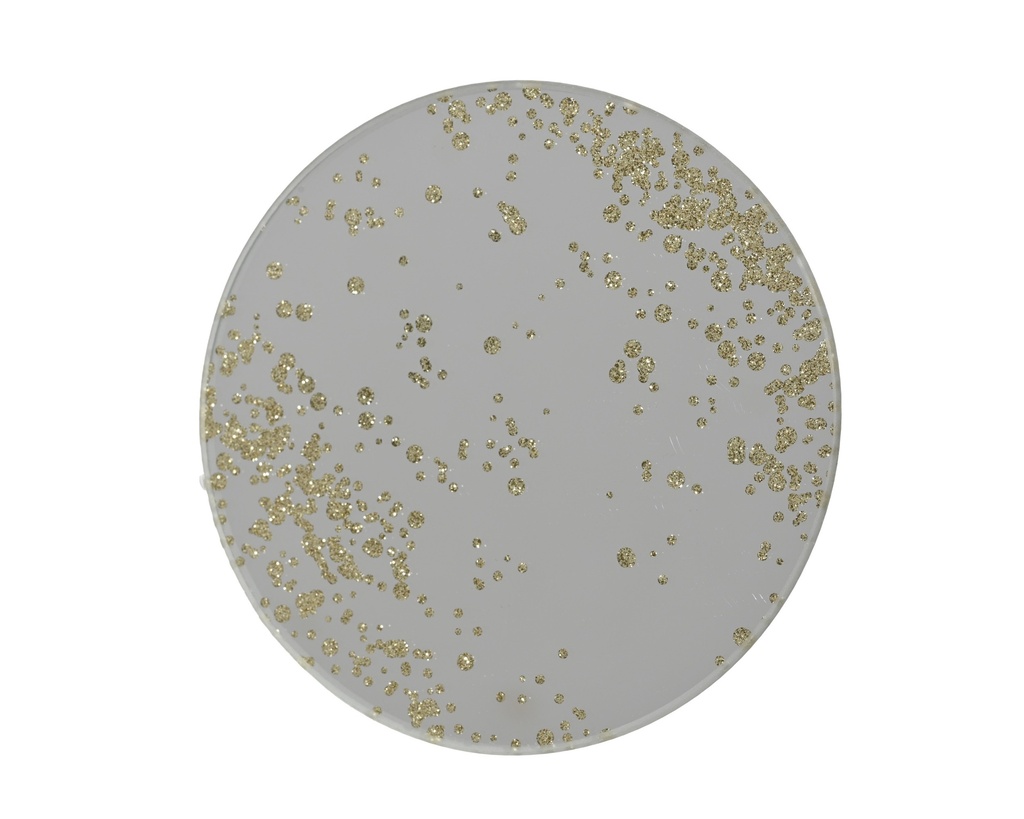
POSAVASOS PLATEADO CON PURPURINA - dia10.00-H0.30cm

POSAVASOS PLATEADO CON PURPURINA - dia10.00-H0.30cm
Code: 4-383008 | Plate glass round | Indoor/outdoor:indoor | Shape:Round | Size: dia10.00-H0.30cm Color: silver | Packaging: 48/48 in Pieces Sticker | EAN: 8720725181304
Referencia interna:
4-383008
Medidas:
dia10.00-H0.30cm
Código de barras:
8720725181304
Color:
silver
Origen:
2026-X
Tendencia:
Christmas Beauty
Filtre Temp:
0